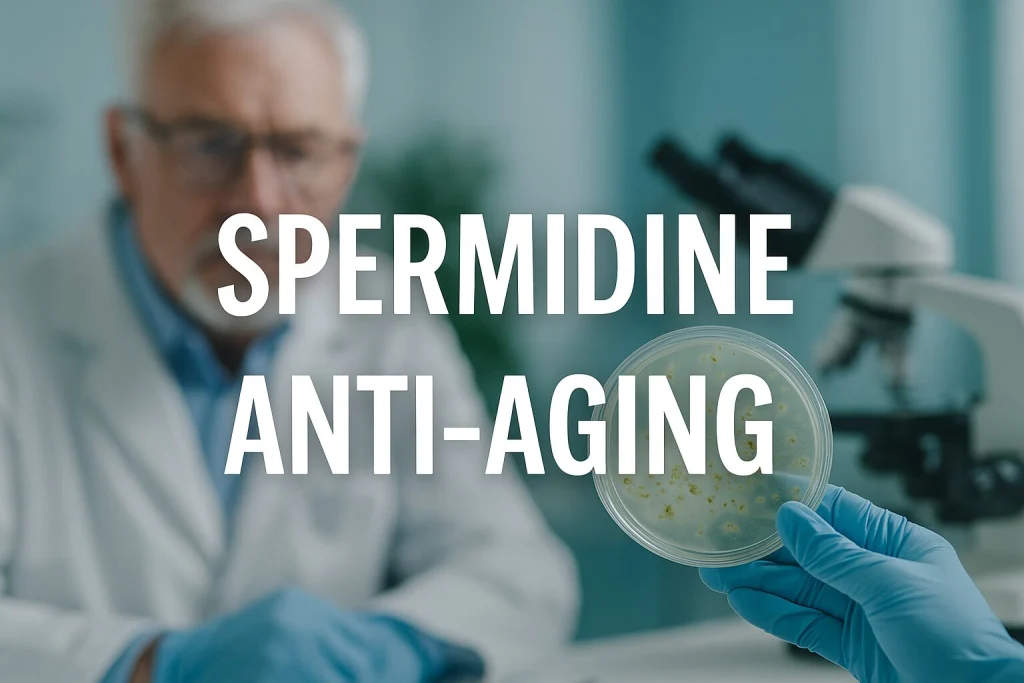
spermidine anti-aging

Welcome to the Simply Anti-Aging Blog, your science-first source for understanding how to reduce biological age, improve longevity, and apply real-world biohacks. Here you’ll find practical guides, aging myth busters, and evidence-based tips to help you feel younger, longer.